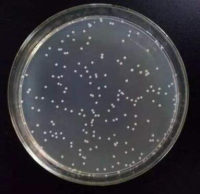
OrigamiB(DE3) 感受态细胞(化转)/ OrigamiB(DE3) chemically Competent Cells

相关产品推荐更多 >
万千商家帮你免费找货
0 人在求购买到急需产品
- 详细信息
- 技术资料
- 保存条件:
-80℃
- 保质期:
6个月
- 英文名:
K599 Chemically Competent Cell
- 库存:
10支
- 供应商:
上海富雨
- 规格:
100ul
K599 Chemically Competent Cell上海富雨生物简介
上海富雨生物科技有限公司(Shanghai Fuyu Biotechnology Co., Ltd)面向国际市场专业研发、生产和销售ELISA试剂盒、抗体、重组蛋白及相关试剂。产品在免疫学、信号转导、代谢、神经科学等领域内都有最前沿科学文献发表,被国内外多所大学、研究机构和药学平台使用并发表文献多达1000多次。产品主销国外市场,在40多个国家设有代理商,全球合作商达100余个。上海富雨生物科技有限公司凭借优异的产品和完善的服务体系现已受到广大国内外用户的青睐和认可。科研好帮手,专业生产商
品牌优势
1、产品优势:产品具有高特异性、回收率高、线性好、变异系数低、稳定性好;
2、质量保证:产品质量稳定,每批次产品必须通过QA、QC检测才可出库;
3、实力强大: 标准实验室、研发中心,动物房 ;
4、技术支持:技术部5*8小时技术问题及时解答;
5、服务周到:发货及时,三个工作日顺丰快递;售后无忧,包退包换。
研发、生产科研产品:ELISA试剂盒:多种属、1000多种指标:人、大小鼠、通用、牛、兔、山羊、仓鼠、猪、马、鸡、犬、豚鼠、猴、绵羊
抗体:兔多抗、鼠单抗种类丰富,一抗1万余种,二抗100多种;
重组蛋白:多项发明专利,原核表达系统稳定表达蛋白1000余种。K599 感受态细胞 K599 感受态细胞 K599 感受态细胞 K599 感受态细胞 K599 感受态细胞 K599 感受态细胞
联系电话:18956075901 (同微信) ,QQ: 3375724714
上海富雨生物科技有限公司(Shanghai Fuyu Biotechnology Co., Ltd)面向国际市场专业研发、生产和销售ELISA试剂盒、抗体、重组蛋白及相关试剂。产品在免疫学、信号转导、代谢、神经科学等领域内都有最前沿科学文献发表,被国内外多所大学、研究机构和药学平台使用并发表文献多达1000多次。产品主销国外市场,在40多个国家设有代理商,全球合作商达100余个。上海富雨生物科技有限公司凭借优异的产品和完善的服务体系现已受到广大国内外用户的青睐和认可。科研好帮手,专业生产商
品牌优势
1、产品优势:产品具有高特异性、回收率高、线性好、变异系数低、稳定性好;
2、质量保证:产品质量稳定,每批次产品必须通过QA、QC检测才可出库;
3、实力强大: 标准实验室、研发中心,动物房 ;
4、技术支持:技术部5*8小时技术问题及时解答;
5、服务周到:发货及时,三个工作日顺丰快递;售后无忧,包退包换。
研发、生产科研产品:ELISA试剂盒:多种属、1000多种指标:人、大小鼠、通用、牛、兔、山羊、仓鼠、猪、马、鸡、犬、豚鼠、猴、绵羊
抗体:兔多抗、鼠单抗种类丰富,一抗1万余种,二抗100多种;
重组蛋白:多项发明专利,原核表达系统稳定表达蛋白1000余种。K599 感受态细胞 K599 感受态细胞 K599 感受态细胞 K599 感受态细胞 K599 感受态细胞 K599 感受态细胞
联系电话:18956075901 (同微信) ,QQ: 3375724714
风险提示:丁香通仅作为第三方平台,为商家信息发布提供平台空间。用户咨询产品时请注意保护个人信息及财产安全,合理判断,谨慎选购商品,商家和用户对交易行为负责。对于医疗器械类产品,请先查证核实企业经营资质和医疗器械产品注册证情况。
K599 感受态细胞
¥320 - 483